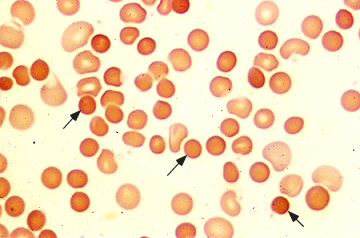

Anciano con dolores óseos, anemia normocítica, VSG elevada, hipercalcemia y paraproteinemia
Mieloma múltiple
Como diferenciamos una leucemia aguda de una leucemia crónica?
Las leucemias agudas (LA) se definen por >20% blastos en médula ósea y pueden presentarse con una cifra de leucocitos en sangre periférica elevada, normal o baja, a expensas de formas inmaduras. Las leucemias crónicas (LC) suelen presentarse con afectación de médula ósea (aunque no se ha establecido un límite como para las LA) y leucocitosis, a expensas de formas maduras
Características intermedias entre un LINFOMA(adenopatías, masa mediastínica, hepatoesplenomegalia) y un MIELOMA multiple (lesiones óseas líticas e hipercalcemia).. Dx?
Leucemia-linfoma de células T del adulto, infección por HTLV-I
Los dacrocitos o hematíes en lágrima son típicos de…
la mieloptisis
Que cuadro clínico da la EICH aguda?
La EICH aguda se caracteriza por afectación cutánea (típicamente afecta “palmas y plantas”), hepática (“coloración amarillenta”) e intestinal (“sufre diarreas importantes”)
Que es la hepcidina y como están sus niveles en la anemia de enfermedad crónica?
Es una proteína producida en el hígado que regula el metabolismo del hierro disminuyendo la absorción intestinal e impide su liberación de los depósitos en macrófagos. Se INCREMENTA en procesos inflamatorios
Hasta que edad se hace trasplante alogénico de precursores hematopoyéticos como tto de la aplasia medular?
Hasta los 45 años
Cuales son las principales fuentes de vit B12?
Carne y vísceras
Donde se conjuga la vit B12 con el factor intrínseco?
En el duodeno, por acción de una lipasa pancreática
Donde se absorbe la vit B12?
En el íleon
El reservorio principal de vit B12 se localiza en…
el hígado
Pancitopenia + ferropenia + insuficiencia renal + trombosis
Hemoglobinuria paroxística nocturna
Que es el síndrome de Zive?
el síndrome de las 3H: Hemólisis; Hepatopatía; Hiperlipemia
Pancitopenia + VCM elevado + alteración de la absorción (gastrectomía) + LDH y bilirrubina aumentados + coombs (-) + neutrófilos hipersegmentados
Anemia megaloblástica
Cuanto tiempo tenemos que tratar con hierro para corregir una anemia ferropénica?
Hierro durante 3-6 meses que es cuando se normaliza la ferritina
Que haremos si no se corrige la anemia ferropenica con hierro oral?
1) insistir en la toma correcta de hierro
2) buscar sangrado oculto
3) buscar trastorno malabsortivo (celiaquía, H.pylori)
Como están los niveles de homocisteína en la anemia megaloblastica por déficit de B12 y por déficit de ácido fólico
Elevada en las dos
Como están los niveles de ácido metilmalónico en la anemia megaloblastica por déficit de B12 y por déficit de ácido fólico
Elevados en déficit vit B12 normales en déficit ácido fólico
Los pacientes con estados hemolíticos crónicos compensados pueden desarrollar una aneia severa si se produce:
Clínica de anemía hemolítica con VCM disminuido (microesferocitosis) i aumento CCHM, que Dx sospechamos?
Esferocitosis hereditaria, son hematíes que tienen la misma Hb pero como su superfície es menor hay, relativamente, mayor concentración de Hb
Anemias hemolíticas intravasculares
Clínica de las anemias hemolíticas intravasculares
Disminución de haptoglobina y orina oscura (hemoglobinuria, hemosideruria)
Clínica anemias hemolíticas extravasculares (= bazo)
Esplenomegalia, icterícia (aumento bilirrubina indirecta), colelitiasis
Valores de normalidad hemoglobina